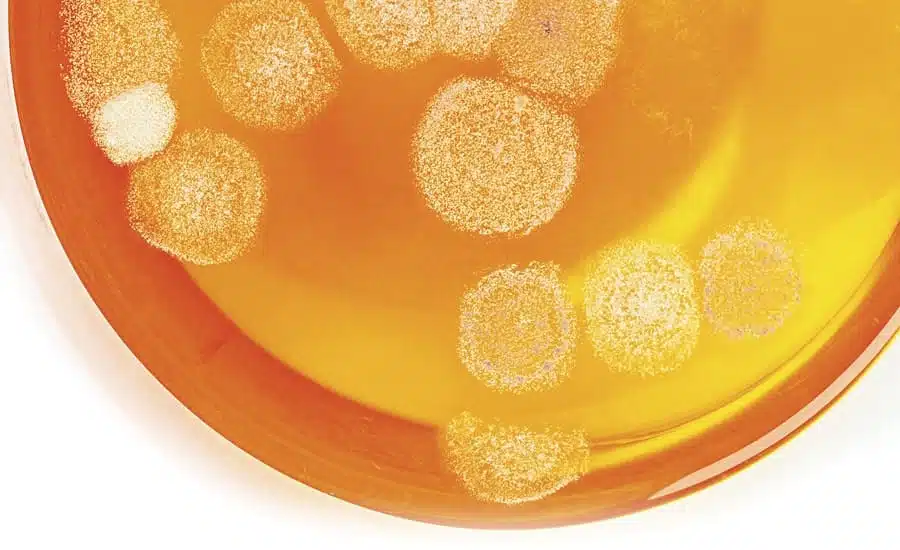

قبل از خرید نگهدارنده بخوانید!

نگهدارنده ها موادی هستند که به محصولات آرایشی و بهداشتی اضافه می شوند تا از رشد و نمو میکروارگانیسم ها در محصول جلوگیری کنند. از این رو نگهدارنده ای مفید و کارآمد است که محصول را از تاریخ تولید تا تاریخ انقضاء از گزند میکروارگانیسم ها محافظت نماید. به طور کلی نگهدارنده ها مانع رشد […]
مکانیسم عملکرد برونوپل بر میکروارگانیسم ها
چکیده در این مقاله به تفاوت مواد باکتری ساید و باکتری استاتیک پرداخته می شود . عملکرد باکتری استاتیک برونوپل شرح داده می شود. تاثیر منفی گروه عاملی تیول بر فعالیت برونوپل شرح داده می شود در نهایت به این موضوع پرداخته می شود که مواد اولیه تشکیل دهنده دترجنت ها تاثیری روی فعالیت […]